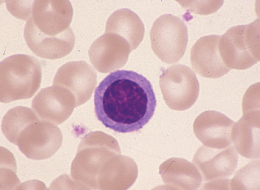

前 略
今冬は自然界の猛威になすすべもない日々でしたがお変わりないでしょうか。
小生、60歳を過ぎ二回目の成人式に向かってどうにか真っ直ぐ歩んでおります。
“雪舞いに幸の訪れ兎に託し”を念頭の詠みとして、この一年を乗り越えるつもりです。
さて、厳寒の冬に背かうことなく閉店しておりました「マンスリーマガジン」ですが、皆様からの叱咤激励をいただき、ようやく重き鉛腰を持ち上げることになりました。
通い慣れた道端に目をやれば、草木の芽はみなぎり、小川の水は温みはじめ、川うらら、山うらら、海うららの来春をサメ肌に感じております。
くすんでばかりいてはいけません。陽光を求めそろそろ活動しなければなりま せん。只今、新作の準備中ですので、今しばらくお待ちください。
以上、今年もおてやわらかにお願いいたします。
草々
形態マガジン号キャプテン 阿南 建一 
CASE 1~5の細胞を同定してください。また、同定した理由についてもそれぞれの所見から選択してください。
PB-MG.600

PB-MG.600

PB-MG.600

PB-MG.600

PB-MG.600

| CASE 1 | CASE 2 | CASE 3 | CASE 4 | CASE 5 | |
|---|---|---|---|---|---|
| 正解細胞 | リンパ球(大型) | 単球 | 単球 | 異型リンパ球 | リンパ球(小型) |
| 細胞の大きさ | 13μm以上 | 13μm以上 | 13μm以上 | 13μm以上 | 13μm以下 |
| N-C比 | 低い | 低い | 低い | 低い | 低い |
| 核形不整 | なし | あり | あり(陥没) | あり(陥没) | なし |
| 核小体 | なし | なし | なし | なし | なし |
| 核網(クロマチン) | 粗鋼 | 繊細 | 繊細 | 粗鋼 | 粗鋼/結節状 |
| 細胞質の色調 | 弱好塩基性 | 灰青色 | 灰青色 | 部分的好塩基性 | 全体的好塩基性 |
| 細胞質の顆粒 | なし | なし | なし | なし | なし |
| 細胞質の封入体 | なし | なし | なし | なし | なし |
| 細胞質の突起 | なし | なし | なし | なし | なし |
解説の前に形態観察の着眼とすすめ方について私見を述べます。
まず、細胞の大きさから始め、核の所見、そして細胞質の所見へと観察していきます。しかし、細胞によっては核と細胞質の所見の優先順位をずらして観察しないといけない場合があります。
例として顆粒球系と赤芽球系細胞を挙げてみましょう。まず、観察の優先順を決めるため、一次ポイントと二次ポイントに分け、優先する方を一次ポイントにしてそうでない方を二次ポイントにします。二次ポイントになるのは二次的変化を有するものが相当します。
一般に、顆粒球系細胞の二次的変化として細胞質に低(脱)顆粒や異常なほど顆粒が出現する場合があるため、細胞質が二次ポイントになります。
一方、赤芽球系細胞の二次的変化として核にDNA障害による核の遅延現象が起こる場合があるため、核が二次ポイントになります。
従って、顆粒球系細胞では核が一次ポイントになり得ますので核を優先にして観察し、赤芽球系細胞では細胞質が一次ポイントになり得ますので細胞質を優先して観察をおこなうことになります。


細胞の大きさは直径18μm大で、N-C比は低いようです。
N-C比についてJSLH*では核の占める割合が80%以上を示す場合、大きいもしくは高いとしています。核形の不整はなく類円形で、核網は粗鋼、核小体は中央にありそうですが鮮明でないため “なし”と判定しました。
細胞質は淡青色で秋の澄み切った青空を想定させるもので顆粒は認めません。形状からリンパ球を考え、N-C比が低い、核形不整がな いことよりリンパ球(大型)と同定しました。
*JSLH:日本検査血液学会


細胞の大きさは直径17μm大で、N-C比は低いようです。
核形の不整があり、核網は繊細、核小体は不明のようです。細胞質は灰青色の曇り空を想定させるもので顆粒は認めません。
核網が繊細で、核形不整は特徴的な切れ込みを認め、細胞質のくすんだ色調より単球と同定しました。CASE1.との核網の違いを読み取ることが重要と思われます。


細胞の大きさは直径22μm大で、N-C比は低いようです。
核形の不整は核内への強度の陥没があり、核網は繊細、核小体は不明のようです。細胞質は灰青色の曇り空を想定させ空胞があり顆粒は認めません。
核網が繊細、核形不整派顕著で、細胞質のくすんだ色調より単球と同定しました。本細胞の特徴である核形不整については核内への陥没を思わせるが、CASE2.は核内への切れ込みを思わせます。


細胞の大きさは直径18μm大で、N-C比は低いようです。
核は偏在性で核形の不整は軽度の陥没がみられ、核網は粗鋼、核小体は不明のようです。細胞質は部分的な好塩基性がみられ顆粒は認めません。
形状からリンパ球を考え、16μmより大の大きさと軽度の核形不整、核網の粗荒、細胞質の部分的な好塩基性より異型リンパ球(単球類似)と同定しました。


細胞の大きさは直径9μm大の小型で、N-C比は低いようです。
核は円形で不整はみられず、核網は粗鋼(結節状)、核小体は不明のようです。細胞質は全般に好塩基性がみられ顆粒は認めません。形状からリンパ球を考え、
13μmより小型の大きさより小型リンパ球と同定しました。小型リンパ球はこのように好塩基性の細胞質を有しますので異型リンパ球と間違わないようにしなければなりません。


細胞の大きさは直径18μm大で、N-C比は低いようです。
N-C比についてJSLH*では核の占める割合が80%以上を示す場合、大きいもしくは高いとしています。核形の不整はなく類円形で、核網は粗鋼、核小体は中央にありそうですが鮮明でないため “なし”と判定しました。
細胞質は淡青色で秋の澄み切った青空を想定させるもので顆粒は認めません。形状からリンパ球を考え、N-C比が低い、核形不整がな いことよりリンパ球(大型)と同定しました。
*JSLH:日本検査血液学会


細胞の大きさは直径17μm大で、N-C比は低いようです。
核形の不整があり、核網は繊細、核小体は不明のようです。細胞質は灰青色の曇り空を想定させるもので顆粒は認めません。
核網が繊細で、核形不整は特徴的な切れ込みを認め、細胞質のくすんだ色調より単球と同定しました。CASE1.との核網の違いを読み取ることが重要と思われます。


細胞の大きさは直径22μm大で、N-C比は低いようです。
核形の不整は核内への強度の陥没があり、核網は繊細、核小体は不明のようです。細胞質は灰青色の曇り空を想定させ空胞があり顆粒は認めません。
核網が繊細、核形不整派顕著で、細胞質のくすんだ色調より単球と同定しました。本細胞の特徴である核形不整については核内への陥没を思わせるが、CASE2.は核内への切れ込みを思わせます。


細胞の大きさは直径18μm大で、N-C比は低いようです。
核は偏在性で核形の不整は軽度の陥没がみられ、核網は粗鋼、核小体は不明のようです。細胞質は部分的な好塩基性がみられ顆粒は認めません。
形状からリンパ球を考え、16μmより大の大きさと軽度の核形不整、核網の粗荒、細胞質の部分的な好塩基性より異型リンパ球(単球類似)と同定しました。

細胞の大きさは直径9μm大の小型で、N-C比は低いようです。
核は円形で不整はみられず、核網は粗鋼(結節状)、核小体は不明のようです。細胞質は全般に好塩基性がみられ顆粒は認めません。形状からリンパ球を考え、
13μmより小型の大きさより小型リンパ球と同定しました。小型リンパ球はこのように好塩基性の細胞質を有しますので異型リンパ球と間違わないようにしなければなりません。
これから先のページでは、医療関係者の方々を対象に医療機器・体外診断薬等の製品に関する情報を提供しております。当社製品を適正に使用していただくことを目的としており、一部の情報では専門的な用語を使用しております。
一般の方への情報提供を目的としたものではありませんので、ご了承ください。
医療関係者の方は、次のページへお進みください。
(お手数ですが、「進む」ボタンのクリックをお願いします)